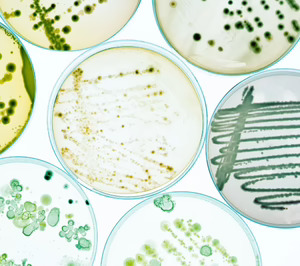
FourStrain Lab, fermentación de precisión con vocación industrial para ingredientes con sentido

La escasez de proyectos en fermentación de precisión afiliados al ecosistema foodtech nacional nos hace celebrar y traer hoy a nuestra newsletter la iniciativa de FourStrain Lab, que acaba de desembarcar en la tercera edición de StartBEC. Esta joven startup está construyendo una plataforma biotecnológica para llevar la fermentación de precisión al terreno industrial y comercial, desarrollando ingredientes funcionales y sostenibles "que tengan sentido" para impactar en las industrias alimentaria, nutracéutica y cosmética. Aunque quizás habría que citar estos sectores en orden inverso.